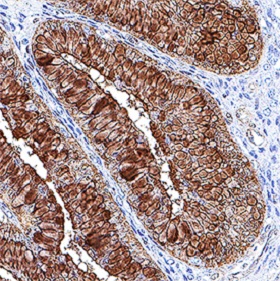
辣根过氧化物酶标记羊抗大鼠IGG

辣根过氧化物酶标记羊抗大鼠IGG
Goat anti-rat IgG/HRP
询价
200ug
起订
江苏 更新日期:2026-04-05
产品详情:
- 中文名称:
- 辣根过氧化物酶标记羊抗大鼠IGG
- 英文名称:
- Goat anti-rat IgG/HRP
- 产品类别:
- 抗体
公司简介
常州贝源鑫生物科技有限公司坐落于历史悠久、人文荟萃的长三角洲经济区域中心地带的江苏常州龙城风景旅游度假区和高新技术产业区为一体的高新产业科学园,是一家专业从事“产品研发生产、市场销售、技术服务”为一体的高科技生物科技公司。 常州贝源鑫生物科技有限公司主供应产品:一、ELISA试剂盒:(人、大鼠、小鼠、豚鼠、猪、牛、羊、猴、兔、犬、鱼、虾、植物微生物农残类种属试剂盒) 二、生化试剂:染色液、氨基酸、酶、色素、维生素、蛋白质、抗生素、缓冲剂、碳水化合物、表面活性剂、植物激素及核酸、层析色谱凝胶、分离材料及耗材等实验用品。 三、动物血清:(新生牛、马、山羊、绵羊、大牛、小牛、猪、鸡、兔、豚鼠、小鼠)、动物全血、动物血浆 四、抗体:Abcam、 CST 、Santa、BD(原装进口,货期短,折扣低) 五、培养基:GIBCO、HYCIONE、CORNING等 六、标准品:DRE、EP、USP、TRC、不仅经销美国Accustandard、Chemservice、CIL(美国剑桥)、Sigma公司的产品,还是挪威Chiron标准品公司和意大利Chromogenix试剂公司、LGC(英国化学家实验室)、加拿大TRC、Chromadex(美国中草药)的中国大陆指定代理商,还同时销售EP(欧洲药典)、USP(美国药典)、BP(英国药典)、(WHO)世界卫生组织药物标准品、医药杂质标准品、N
| 成立日期 | (12年) |
| 注册资本 | 100.000000万人民币 |
| 员工人数 | 10-50人 |
| 年营业额 | ¥ 500万-1000万 |
| 经营模式 | 贸易 |
| 主营行业 | 生化试剂,抗体 |
辣根过氧化物酶标记羊抗大鼠IGG相关厂家报价 更多
-

- 辣根过氧化物酶标记羊抗大鼠IGG
- 上海万生昊天生物技术有限公司
- 2026-04-05
- 询价
-

- 抗小鼠IgG,辣根过氧化物酶(HRP)偶联抗体(二抗)
- 上海优宁维生物科技股份有限公司 VIP
- 2026-04-07
- 询价
-

- 酶类标记辣根过氧化物酶HRP9003-99-0威德利零售
- 湖北威德利化学试剂有限公司 VIP
- 2026-04-07
- ¥985
-

- 辣根过氧化物酶标记羊抗人IGG
- 上海禾午生物科技有限公司
- 2026-04-05
- 询价